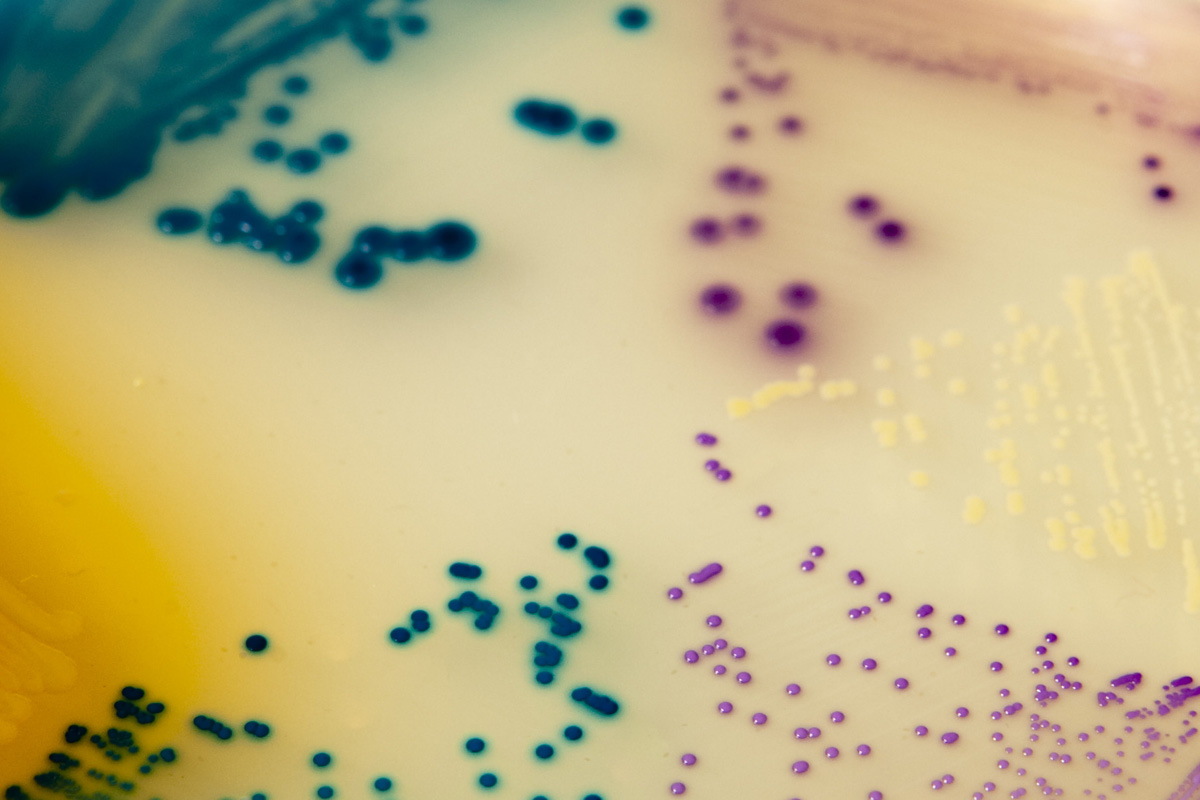

À propos du produit
Milieu chromogène de différenciation et d’identification présomptive des bacilles gram-négatifs et espèces d’Enterococcus.
Produits
Milieux et suppléments
Géloses Chromogènes CHROMagar
CHROMAGAR ORIENTATION (boîtes opaques)
CHROMAGAR ORIENTATION (boîtes opaques)

Milieu chromogène de différenciation et d’identification présomptive des bacilles gram-négatifs et espèces d’Enterococcus.